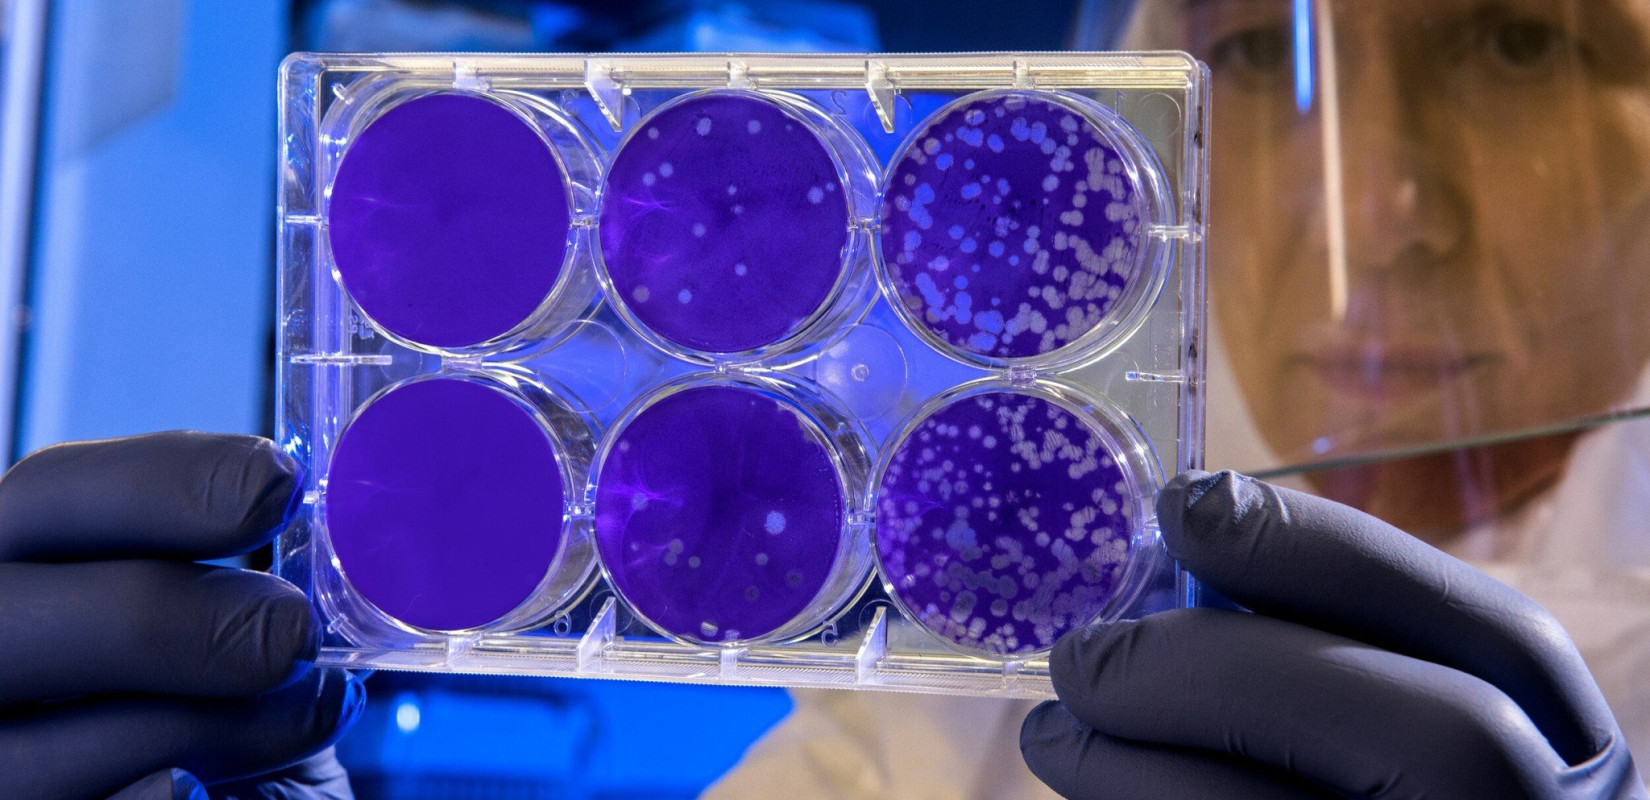
Πώς μπορεί να εισέλθει η ευλογιά των πιθήκων στην Ελλάδα; - Ο πρόεδρος του ΕΟΔΥ εξηγεί (βίντεο)

Σε καθεστώς επιτήρησης η Ηλεία για τον στρεπτόκοκκο: Δύο νεκροί και ένας σε σοβαρή κατάσταση στο νοσοκομείο Πατρών (βίντεο)
Kλιμάκια του ΕΟΔΥ μετέβησαν στο Νοσοκομείο Πύργου και λαμβάνουν τυχαία δείγματα με αιμοληψίες από διαφορά περιστατικά
Για την έξαρση κρουσμάτων στρεπτόκοκκου, ο κ. Χατζηχριστοδούλου είπε πως «πρέπει έγκαιρα να πηγαίνουμε στο γιατρό όταν έχουμε πυρετό, είτε εμείς είτε τα παιδιά μας και ο γιατρός να κάνει τη διάγνωση και να χρησιμοποιεί πολύ πιο εύκολα το στρεπ τεστ»
Κάνε κλικ και δες περισσότερο emakedonia.gr στην αναζήτηση της Google
Πρόσθεσέ το στην Google- Newsroom
Ο πρόεδρος του ΕΟΔΥ, Χρήστος Χατζηχριστοδούλου, μίλησε στο ΕΡΤNews για τα κρούσματα στρεπτόκοκκου που φτάνουν να είναι θανατηφόρα αλλά και για την ευλογιά των πιθήκων ή «mpox» και την εξάπλωσή της μετά και το πρώτο κρούσμα επί ευρωπαϊκού εδάφους και συγκεκριμένα στη Σουηδία.
«Περιμένουμε περισσότερα εισαγόμενα κρούσματα και ειδικά από άτομα που επισκέπτονται τις περιοχές που είναι επηρεαζόμενες αυτή τη στιγμή και ειδικά τη Λαϊκή Δημοκρατία του Κονγκό και μάλιστα εκεί αύξησε το CDC τον κίνδυνο σε μέτριο, ειδικά όμως για τους επισκέπτες σε αυτές τις περιοχές» τόνισε ο κ. Χατζηχριστοδούλου.
Σχολιάζοντας το ενδεχόμενο εισαγόμενων κρουσμάτων, εξήγησε ότι άτομα που εργάζονται εκεί και θα επιστρέψουν πίσω, είτε που επισκέπτονται τις περιοχές που αυτή τη στιγμή υπάρχουν κρούσματα, είτε στο Κογκό, είτε στις γειτονικές χώρες, θα μπορούσαν να γυρίσουν πίσω και εφόσον εκτεθούν σε άτομα τα οποία ήδη νοσούν εκεί με οποιοδήποτε τρόπο, ενδεχομένως να κολλήσουν και να μεταφέρουν τον ιό. «Επειδή έχει μεγάλο χρόνο επώασης, μπορεί να έρθουν εδώ υγιείς και μετά να εκδηλώσουν το νόσημα, ενώ είναι στην Ελλάδα» πρόσθεσε..
Όσον αφορά στον εμβολιασμό, ο κ. Χατζηχριστοδούλου τόνισε ότι προς το παρόν η σύσταση είναι μόνο για τις ομάδες υψηλού κινδύνου. «Θα μείνουμε εκεί και θα δούμε πώς θα εξελιχθεί το όλο φαινόμενο» είπε.
Όσον αφορά στην έξαρση του στρεπτόκοκκου, ο πρόεδρος του ΕΟΔΥ σημείωσε ότι μετά την πανδημία του covid παρατηρήθηκε ότι πολλές χώρες ευρωπαϊκές παρουσίασαν αύξηση των κρουσμάτων αυτών και σοβαρά νοσήματα και θανάτους.
«Πρέπει έγκαιρα να πηγαίνουμε στο γιατρό όταν έχουμε πυρετό, είτε εμείς είτε τα παιδιά μας και ο γιατρός να κάνει την διαφορική διάγνωση και να χρησιμοποιεί πολύ πιο εύκολα το στρεπ τεστ. Δεν το συνιστώ να το κάνουμε μόνοι οι γονείς γιατί εκεί έχουμε λανθασμένο τρόπο εκτέλεσης και λανθασμένα αποτελέσματα» συμβούλευσε.
Πηγή: ertnews.gr
Κάνε κλικ και δες περισσότερο emakedonia.gr στην αναζήτηση της Google
Πρόσθεσέ το στην GoogleKλιμάκια του ΕΟΔΥ μετέβησαν στο Νοσοκομείο Πύργου και λαμβάνουν τυχαία δείγματα με αιμοληψίες από διαφορά περιστατικά
Θα είχαν μεγαλύτερες πιθανότητες να αντιμετωπίσουν τη νόσο, ακόμη και μετά τον εντοπισμό ενός κρούσματος στην Ευρώπη, σύμφωνα με τον Λ.Ε. Ζάντερ
Σύμφωνα με τον ΠΟΥ ο ιός έχει αυτή τη στιγμή τη δυνατότητα να εξαπλωθεί σε ολόκληρο τον κόσμο, εάν το επιτρέψουν οι συνθήκες
Το 98% των περιπτώσεων mpox αφορά άνδρες και το 39% των περιπτώσεων είναι ηλικίας 31-40 ετών - Τι επισημαίνουν οι υπεύθυνοι του Ευρωπαϊκού Κέντρου Ελέγχου Νοσημάτων σε σχέση με όσους έχουν ταξιδέψει σε πληγείσες χώρες και όσους δεν έχουν ταξιδέψει
